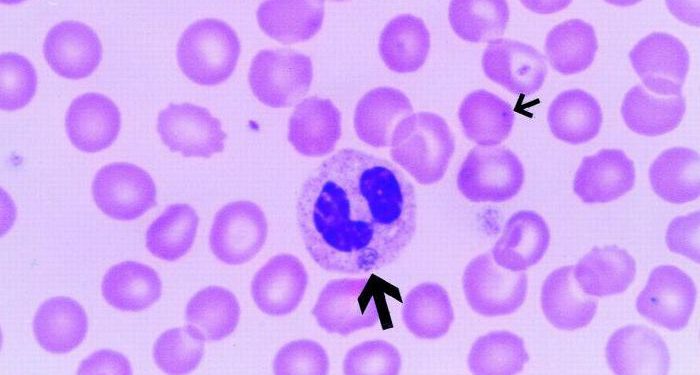
Гранулоцитарный эрлихиоз человека 1 Гранулоцитарный эрлихиоз человека

Синонимы гранулоцитарного эрлихиоза человека (ГГЭ)
- HGE
- человеческая эрлихиальная инфекция, гранулоцитарный тип человека
Обсуждение
Человеческий гранулоцитарный эрлихиоз (ГГЭ) является редким инфекционным заболеванием, которое относится к группе заболеваний, известных как человеческий эрлихиоз. Эрлихиозы — это инфекционные заболевания, вызываемые бактериями в семье «Эрлихия». Было выявлено несколько форм человеческой эрлихиальной инфекции, включая гранулоцитарный эрлихиоз человека (HGE), лихорадку Сеннецу и моноцитарный эрлихиоз человека (HME). Хотя расстройства вызваны различными штаммами бактерий Эрлихии, все расстройства характеризуются сходными симптомами.
Симптомы гранулоцитарного эрлихиоза человека (ГГЭ) могут включать внезапную высокую температуру, головную боль, мышечные боли (миалгию), озноб и общее чувство слабости и усталости (недомогание) в течение недели или около того после начальной инфекции. В большинстве случаев могут возникать аномальные лабораторные данные, включая аномально низкое количество тромбоцитов циркулирующей крови (тромбоцитопения), уменьшение лейкоцитов (лейкопения) и аномальное повышение уровня некоторых ферментов печени (печеночных трансаминаз). В некоторых случаях симптомы могут прогрессировать, включая тошноту, рвоту, кашель, диарею, потерю аппетита (анорексию) и / или спутанность сознания. Если гранулоцитарный эрлихиоз человека не лечить, в некоторых случаях могут развиться такие угрожающие жизни симптомы, как почечная недостаточность и / или проблемы с дыханием. Гранулоцитарный эрлихиоз человека вызван бактерией семейства эрлихиозов, которая еще не была названа. Эрлихиальная бактерия переносится и передается определенными клещами (переносчиками), такими как клещ оленя (Ixodes scapularis) и клещ американской собаки (Dermacentor variabilis).
Признаки и симптомы
У людей с гранулоцитарным эрлихиозом человека (ГГЭ) появление симптомов обычно происходит примерно через неделю после того, как человека покусал клещ, несущий бактерию Эрлихии. Конкретный штамм бактерии Ehrlichia, ответственный за ГГЭ, еще не назван. Почти во всех случаях симптомы включают лихорадку, озноб, мышечные боли (миалгия), общее чувство слабости и усталости (недомогание) и / или головные боли.Некоторые больные могут также испытывать кашель, тошноту, рвоту, боль в суставах (артралгия) и / или спутанность сознания. В очень редких случаях на коже может появиться сыпь.
Кроме того, у большинства людей с ГГЭ наблюдается аномальное повышение уровня определенных ферментов печени (печеночных трансаминаз); низкий уровень белка альбумина в крови (гипоальбуминемия);и / или ненормальное снижение уровня тромбоцитов в циркулирующей крови (тромбоцитопения), эритроцитов (анемия) и / или определенных гранулярных лейкоцитов (гранулоцитопения), которые играют роль в удалении бактерий из крови и их уничтожении.
В некоторых серьезных случаях, если гранулоцитарный эрлихиоз человека не лечить, могут развиться угрожающие жизни симптомы, такие как дыхательная недостаточность, сильное желудочно-кишечное кровотечение, почечная (почечная) недостаточность и / или повреждение печени.
Согласно медицинской литературе, в редких случаях люди с HGE могут быть одновременно заражены болезнью Лайма, более распространенным бактериальным заболеванием, которое передается клещами оленей (которые также являются известными векторами клещей для HGE). В таких случаях больные люди могут испытывать симптомы и физические данные, часто связанные с ГГЭ и болезнью Лайма, такие как головная боль, лихорадка, мышечные боли, слабость, боль в суставах (артралгия) и / или нарушения функции печени. Они также могут испытывать определенные симптомы и признаки, характерные для одного расстройства, но редко встречающиеся в другом, такие как появление характерного покраснения кожи (erythemaronicum migrans), которое часто связано с болезнью Лайма, и / или кашель, тромбоцитопения и / или гранулоцитопения, которая часто встречается у лиц с ГГЭ. Согласно медицинской литературе, еще не ясно, может ли коинфекция с ГГЭ и болезнью Лайма привести к более серьезному заболеванию, чем то, которое обычно ассоциируется с инфекцией ГГЭ или болезнью Лайма. (Для получения дополнительной информации о болезни Лайма, пожалуйста, см. Раздел «Связанные нарушения» данного отчета ниже.)
причины
Человеческие эрлихиозы, включая гранулоцитарный эрлихиоз человека (ГГЭ), вызваны бактериями, принадлежащими к семейству «Эрлихия». Эти бактерии передаются человеку через укус зараженных клещей. (Клещи служат «векторами», названием любого организма, который заражен, а затем передает определенный возбудитель болезни (например, бактерию или вирус) другому организму, который затем может заразиться). Клещи, которые могут передавать бактерии, ответственные за ГГЭ, включают клеща оленя (Ixodes scapularis) и клеща американской собаки (Dermacentor variabilis).
Человеческий гранулоцитарный эрлихиоз (ГГЭ) вызывается видом эрлихиальной бактерии, генетически сходным или идентичным с видом, вызывающим эрлихиоз у лошадей (Ehrlichia equi), а также другим штаммом, вызывающим эрлихиальную инфекцию у крупного рогатого скота, оленя, и овцы (Ehrlichia phagocytophila).
В ГГЭ бактерии Эрлихиала внедряются и, если их не лечить, в конечном итоге разрушают (фагоцитоз) определенные белые кровяные клетки (гранулоциты), которые играют роль в защите от инфекции. Инвазивные бактерии образуют характерные мембраносвязанные бактериальные агрегаты (morulae) в цитоплазме клетки-хозяина.
Затронутые группы населения
До недавнего времени эрлихиозы были известны прежде всего как ветеринарные расстройства. Однако у человека обнаруживаются две формы инфекции: гранулоцитарный эрлихиоз человека (ГГЭ) и моноцитарный эрлихиоз человека (ГМЭ). По данным Центров по контролю и профилактике заболеваний, впервые признанным в Соединенных Штатах в 1986 году, человеческие эрлихиозы считаются возникающими зоонозами (болезнями животных, которые могут передаваться человеку в естественных условиях).
Национальные показатели заболеваемости не были определены из-за широкой изменчивости в отчетности. Центр контроля заболеваний призвал улучшить национальный эпиднадзор за эрлихиозом. Между тем, с 1986 по 1997 год, согласно отчету CDC 1999 года, департаменты здравоохранения штата сообщили о 1223 случаях (742 HME, 449 HE и 32 не приписаны конкретному агенту).
О ГГЭ чаще сообщалось в северо-восточных и верхних средне-западных штатах, в то время как о ГМЭ чаще сообщалось в юго-восточных и южно-центральных штатах. Различное географическое распределение человеческих эрлихиозов может быть результатом различий в распределении различных видов клещей, которые действуют как векторы для бактерий.
Хотя заражение ГГЭ может происходить в любое время года, оно чаще всего встречается в июне и июле. Теоретически, эта болезнь поражает мужчин и женщин в равных количествах. Однако в наблюдаемых случаях примерно 80 процентов пострадавших — мужчины, а около 20 процентов — женщины.Инфекция имеет тенденцию происходить, когда люди участвуют в развлекательных или профессиональных действиях, которые подвергают их воздействию клещей-переносчиков.
В редких случаях люди с ГГЭ могут быть одновременно инфицированы болезнью Лайма, инфекционным заболеванием, вызванным бактерией спирохеты Borrelia burgdorferi. Коинфекция может возникать из-за того, что процент клещей оленей в определенных географических районах может быть заражен бактериальными агентами как для ГГЭ, так и для болезни Лайма. В пригороде Нью-Йорка было обнаружено, что от 2,2% до 26% клещей оленей были совместно заражены агентами для ГГЭ и болезни Лайма.
Связанные расстройства
Симптомы следующих расстройств могут быть схожими с симптомами гранулоцитарного эрлихиоза человека (ГГЭ). Сравнения могут быть полезны для дифференциальной диагностики:
Человеческий моноцитарный эрлихиоз (HME), редкое инфекционное заболевание, вызывается бактерией из семейства «Эрлихия», известной как Ehrlichia chaffeensis. Инвазивные бактерии распространяются через кровеносные и лимфатические сосуды и проникают в определенные клетки, которые играют важную роль в иммунной системе организма (моноциты и макрофаги). У людей с HME появление симптомов обычно происходит примерно через три недели после того, как человек был укушен клещом, переносящим бактерию E. chaffeensis. Симптомы могут первоначально включать лихорадку, озноб, головные боли, мышечные боли (миалгия) и общее чувство слабости и усталости (недомогание). Симптомы могут прогрессировать, включая тошноту, рвоту, потерю аппетита (анорексию) и / или потерю веса. Некоторые больные могут также испытывать кашель, диарею, боль в горле (фарингит), боль в области живота и / или спутанность сознания. Во многих случаях HME также наблюдается аномальное уменьшение лейкоцитов (лейкопения), низкое количество тромбоцитов циркулирующей крови (тромбоцитопения) и / или ненормальное повышение уровня некоторых ферментов печени (печеночных трансаминаз). Некоторые больные могут также испытывать воспаление печени (гепатит). Большинство случаев произошло в среднеатлантических и юго-восточных штатах США.(Для получения дополнительной информации об этом заболевании, выберите «Человеческий моноцитарный эрлихиоз» в качестве поискового термина в базе данных редких заболеваний.)
Лихорадка Сеннецу, редкое инфекционное заболевание, которое также относится к человеческому эрлихиозу, вызывается бактерией, известной как Ehrlichia sennetsu. Симптомы лихорадки Сеннецу могут включать внезапную высокую температуру, головную боль и мышечные боли (миалгию) в течение нескольких недель после первоначальной инфекции. Некоторые больные могут также испытывать тошноту, рвоту и / или потерю аппетита (анорексия).Кроме того, во многих случаях могут возникать аномальные лабораторные результаты, включая уменьшение лейкоцитов (лейкопения) и / или ненормальное повышение уровня определенных ферментов печени (печеночных трансаминаз). Вектор (или носитель) для бактерии E. sennetsu еще не определен; Тем не менее, некоторые исследователи считают, что инфекция может возникнуть в результате приема сырой рыбы. Сообщается, что случаи лихорадки Сеннецу ограничены Западной Японией и Малайзией.(Для получения дополнительной информации об этом заболевании, выберите «Sennetsu» в качестве поискового запроса в базе данных редких заболеваний.)
Самая последняя выявленная форма человеческого эрлихиоза была зарегистрирована у четырех человек в Миссури, причем все они испытывали воздействие клеща за несколько дней до появления симптомов.Основываясь на определенных специализированных лабораторных тестах, четыре человека дали положительный результат на эрлихиальную инфекцию, но отрицательный для всех известных человеческих форм заболевания (например, HGE, HME). Дальнейшие тесты показали, что инфекция была вызвана Ehrlichia ewingii, бактерией, которая ранее считалась вызывающей только Эрлихиальную инфекцию у собак (гранулоцитарный эрлихиоз собак). Исследователи указали, что нет никаких доказательств прямой передачи заболевания от собак к человеку. Скорее, люди и собаки являются хозяевами одних и тех же клещей-переносчиков.Сопутствующие симптомы, как правило, включают лихорадку, головную боль, боль в суставах и мышцах и общее ощущение плохого самочувствия (недомогание). Кроме того, как и при других формах человеческого эрлихиоза, могут также присутствовать аномальные лабораторные данные, такие как аномально низкий уровень циркулирующих тромбоцитов (тромбоцитопения) и уменьшение лейкоцитов (лейкопения). Трое из четырех человек с этой формой Эрлихиоза получали терапию лекарствами, которые подавляют деятельность иммунной системы (иммунодепрессанты). Неясно, влияет ли инфекция бактерией E. ewingii на людей с достаточным функционированием иммунной системы (иммунокомпетентность) или в таких случаях наблюдаются легкие симптомы или их отсутствие (бессимптомное). Поэтому последствия таких выводов еще не поняты. Все люди с этой формой человеческого эрлихиоза ответили на лечение антибиотиком доксициклином. (Для получения дополнительной информации о лечении эрлихиоза человека см. Раздел «Стандартные методы лечения» данного отчета ниже.)
Болезнь Лайма является инфекционным заболеванием, вызываемым бактерией спирохеты Borrelia burgdorferi. Бактерия переносится и передается клещами оленей (Ixodes scapularis), которые также являются известным вектором клещей для гранулоцитарного эрлихиоза человека (HGE). В большинстве случаев болезнь Лайма сначала характеризуется появлением красного кожного поражения (erythemaronicum migrans), которое начинается с небольшого приподнятого круглого пятна (папулы), которое расширяется до диаметра не менее пяти сантиметров. Симптомы могут прогрессировать и включать низкую температуру, озноб, мышечные боли (миалгию), головную боль, общее чувство слабости и усталости (недомогание) и / или боль и тугоподвижность крупных суставов (инфекционный артрит), особенно в колени. Такие симптомы могут возникать в периодических циклах. В тяжелых случаях могут возникнуть сердечная мышца (миокард) и / или неврологические нарушения. Большинство случаев болезни Лайма происходит на северо-востоке США. Тем не менее, случаи произошли в других областях США, а также в других странах, включая Китай, Японию, Австралию и некоторые страны Европы. (Для получения дополнительной информации об этом заболевании, выберите «Лайм» в качестве поискового запроса в базе данных редких заболеваний.)
Бабезиоз — это группа инфекционных заболеваний, вызываемых одноклеточными микроорганизмами (простейшими), принадлежащими к семейству «Бабезия». Считается, что простейшие Babesia обычно переносятся и передаются клещами (переносчиками). Бабезиоз встречается преимущественно у животных; однако, в редких случаях, инфекция Бабезиоза может возникнуть у людей. Известно, что некоторые виды Babesia вызывают инфекцию Babesiosis у людей (например, Babesia microti), а клещ оленя (Ixodes scapularis) является известным вектором. (Клещи оленей также являются известными переносчиками HGE.) Инфекция бабезиоза человека может вызывать повышение температуры, озноб, головную боль, тошноту, рвоту и / или мышечные боли (миалгия). Дополнительные признаки могут включать преждевременное разрушение эритроцитов (гемолитическая анемия), аномальное уменьшение тромбоцитов циркулирующей крови (тромбоцитопения) и лейкоцитов (лейкопения) и / или увеличение селезенки (спленомегалия). Симптомы могут быть слабыми у здоровых людей; Кроме того, у некоторых инфицированных людей симптомы могут отсутствовать (бессимптомно). Тем не менее, тяжелая форма бабезиоза, которая может быть опасной для жизни, если не лечиться, может возникнуть у людей, у которых были удалены селезенки (спленэктомия) или у которых нарушена иммунная система. В Соединенных Штатах бабезиоз является наиболее распространенным в северо-восточных штатах. В редких случаях бабезиоз может возникнуть в Европе. (Для получения дополнительной информации об этом заболевании выберите «Бабезиоз» в качестве критерия поиска в базе данных редких заболеваний.)
Пятнистая лихорадка Скалистых гор — редкое инфекционное заболевание, вызываемое бактерией Rickettsia rickettsii. Бактерия переносится и передается переносчиками клещей, такими как клещ Lone Star (Amblyomma americanum) и клещ американской собаки (Dermacentor variabilis).(Американская собачья клещ также является известным вектором HGE.) Пятнистая лихорадка Скалистых гор характеризуется сильной головной болью, высокой температурой, ознобом, мышечными болями (миалгия) и / или спутанностью. В большинстве случаев кожная сыпь может появиться примерно через два-шесть дней после воздействия клеща; сыпь может сначала появиться на ладонях, запястьях, подошвах, лодыжках и предплечьях, а затем распространиться на лицо, туловище и нижние руки и ноги. Некоторые больные могут также испытывать тошноту, рвоту и / или боль в животе. В некоторых случаях, без ранней диагностики и соответствующего лечения, симптомы могут стать опасными для жизни.Пятнистая лихорадка Скалистых гор характерна для вспышек в различных районах Среднего, Восточного и Юго-Восточного Соединенных Штатов. (Для получения дополнительной информации об этом заболевании выберите «Пятнистая лихорадка Скалистых гор» в качестве поискового запроса в базе данных редких заболеваний.)
Синдром токсического шока — это редкое инфекционное заболевание, вызываемое бактерией Staphylococcus aureus, которая производит и выделяет токсическое вещество (энтеротоксин F). Первоначальные симптомы синдрома токсического шока могут включать внезапную высокую температуру, тошноту, рвоту, диарею, головную боль, боль в горле (фарингит) и / или характерную кожную сыпь, напоминающую плохой солнечный ожог. Более поздние симптомы могут включать спутанность сознания, ненормально низкое кровяное давление (гипотензию) и / или нарушение функции печени. Без ранней диагностики и соответствующего лечения могут возникнуть опасные для жизни симптомы. В большинстве случаев синдром токсического шока встречается у менструирующих женщин, возможно, в связи с длительным использованием тампонов с высокой абсорбирующей способностью. Однако, некоторые женщины, которые не использовали тампоны, и некоторые мужчины были затронуты этим расстройством. (Для получения дополнительной информации об этом заболевании выберите «Токсический шок» в качестве поискового запроса в базе данных редких заболеваний.)
Существуют и другие инфекционные расстройства, которые могут характеризоваться внезапной высокой температурой (лихорадочные расстройства), головной болью, миалгией, тошнотой, рвотой, тромбоцитопенией, лейкопенией и / или другими симптомами, связанными с ГГ. (Для получения дополнительной информации об этих нарушениях выберите точное название заболевания в качестве поискового запроса в базе данных редких заболеваний.)
диагностика
Гранулоцитарный эрлихиоз человека (ГГЭ) может быть диагностирован на основании тщательной клинической оценки, характерных результатов и специализированных лабораторных тестов.
Недавно было доказано, что тест, разработанный в Медицинской школе Йельского университета и на сельскохозяйственной экспериментальной станции в Коннектикуте, является подходящим диагностическим инструментом. Он использует рекомбинантный антиген HE-44, используемый в ELISA (тип иммуноферментного анализа). Когда группа ученых оценила этот метод диагностики путем тестирования нормальных образцов сыворотки от здоровых людей, а также образцов сыворотки от пациентов, у которых, как известно, имеется ГЭГ, они обнаружили, что он правильно идентифицировал 87 процентов образцов от субъектов с подтвержденным ГГЭ.
Анализы крови могут выявить признаки, часто связанные с человеческим эрлихиозом, такие как аномально низкий уровень циркулирующих тромбоцитов (тромбоцитопения), низкий уровень определенных лейкоцитов (лейкопения) и / или повышенный уровень некоторых ферментов печени (таких как аспартатаминотрансфераза [ AST] и аланинаминотрансферазы [ALT]). В некоторых случаях лабораторные анализы могут выявить аномалии спинномозговой жидкости. Кроме того, рентгенография грудной клетки может выявить аномалии в легких (например, легочные инфильтраты, увеличение жидкости в легких).
Исследование мазков крови под микроскопом, в котором используется электронный луч (электронная микроскопия), может выявить скопления бактерий в мембраносвязанных полостях (вакуолях) внутри определенных клеток (то есть периферических нейтрофилов); однако такие кластеры могут не проявляться на ранних стадиях развития инфекции. В некоторых случаях могут проводиться дополнительные специализированные лабораторные анализы, чтобы помочь определить и / или подтвердить диагноз конкретной бактериальной инфекции.
Специализированные лабораторные анализы могут включать косвенные иммунофлуоресцентные анализы (IFA), проводимые на жидкой части крови больного (сыворотка). Антитела, которые представляют собой белки, вырабатываемые определенными лейкоцитами, помогают организму бороться с токсинами и микроорганизмами. В непрямом иммунофлуоресцентном анализе человеческие антитела маркируют специальными флуоресцентными красителями и используют микроскоп с ультрафиолетовым излучением, что позволяет исследователям наблюдать реакцию антител на определенные микроорганизмы.
Тест IFA использовался для подтверждения диагноза всех известных типов человеческой эрлихиальной инфекции. Бактерия, вызывающая гранулоцитарный эрлихиоз человека (ГГЭ), была выделена в 1996 году, и это открытие может привести к улучшению диагностических тестов. HGE может быть подтвержден тестированием IFA, наблюдая ответ антител к бактерии, ответственной за Эрлихиальную инфекцию у лошадей, E. equi, бактерию, которая почти генетически идентична бактерии, вызывающей HGE.
Измеримый диагностический рост ответа антител на бактерии Эрлихии может произойти только через несколько недель после начала гранулоцитарного эрлихиоза человека. В результате первоначальные результаты IFA в сыворотке крови могут быть отрицательными в некоторых случаях. Поэтому в некоторых случаях могут использоваться более чувствительные методы тестирования, которые могут помочь установить раннюю диагностику.
Одним из таких процессов, называемых полимеразной цепной реакцией (ПЦР), является лабораторный метод, в котором последовательности ДНК (которая содержит генетическую информацию организма) можно быстро и многократно копировать. Это позволяет проводить тщательный анализ ДНК, помогая идентифицировать данный организм. ПЦР, проведенная на определенных бактериальных последовательностях ДНК, полученных из образцов крови пациентов, может подтвердить инфекцию Эрлиха человека из-за определенного штамма Эрлихии. ПЦР была использована для ранней диагностики гранулоцитарного эрлихиоза человека.
Информация, содержащаяся в медицинской литературе, указывает на то, что, поскольку может быть трудно дифференцировать эрлихиальную инфекцию человека, такую как гранулоцитарный эрлихиоз человека, от других заболеваний, которые также характеризуются высокой температурой (фебрильными заболеваниями), эрлихиоз следует рассматривать у любого пациента с высокой температурой, тромбоцитопения и лейкопения, которые недавно подверглись воздействию клещей. Если есть подозрение на ГГЭ, лечение не следует откладывать до тех пор, пока диагноз IFA не подтвердит диагноз, поскольку положительный ответ антител может возникнуть только через несколько недель после первоначальной инфекции. Терапия должна начаться как можно скорее после появления симптомов.
В редких случаях люди, у которых есть симптомы и физические данные, связанные с ГГЭ, могут также демонстрировать определенные симптомы, обычно связанные с болезнью Лайма, такие как появление поражения красной кожи (erythemaronicum migrans). В таких редких случаях следует учитывать коинфекцию ГГЭ и болезнью Лайма. Согласно медицинской литературе, совместное заражение бактериальными агентами для ГГЭ и болезни Лайма может быть подтверждено путем выделения обоих организмов из образцов крови.
Стандартные методы лечения
лечение
Лечение гранулоцитарного эрлихиоза человека обычно включает стандартные дозы тетрациклина или, альтернативно, доксициклина. Когда люди с ГГЭ не могут принимать тетрациклиновые антибиотики (противопоказано), хлорамфеникол может быть эффективным. В тяжелых случаях гранулоцитарного эрлихиоза человека может потребоваться госпитализация. Другое лечение симптоматическое и поддерживающее.
Согласно медицинской литературе, в тех редких случаях, когда у пострадавших есть подтвержденный диагноз коинфекции ГГЭ и ранней болезнью Лайма, лечение доксициклином следует рассматривать у тех, кто может переносить препараты тетрациклина.
профилактика
Лицам в географических районах, которые рискуют подвергнуться переносу клещей на эрлихиальную инфекцию, следует рассмотреть возможность принятия определенных мер для предотвращения заражения. Такие шаги должны включать ношение рубашек с длинными рукавами, длинных брюк и шляп; носить светлую одежду, чтобы сделать клещей более заметными;использование средств от насекомых; и тщательно проверять их одежду и кожу (особенно кожу головы и заднюю часть шеи) после того, как они находятся в полях или лесистых местах.
Исследовательская терапия
В начале 1996 года исследователи из Университета Миннесоты выделили бактерию, вызывающую гранулоцитарный эрлихиоз человека (ГГЭ). Теперь, когда исследователи понимают, как стимулировать рост этих бактерий в клеточной культуре, они могут дополнительно изучить природу организма, что может привести к улучшению диагностики и лечения ГГЭ. В настоящее время исследователи работают над разработкой анализа крови, который поможет быстрее и точнее диагностировать гранулоцитарный эрлихиоз человека.
Исследования тропических и других инфекционных заболеваний, таких как человеческий эрлихиоз, продолжаются. Для получения дополнительной информации об этих нарушениях, пожалуйста, свяжитесь со Всемирной организацией здравоохранения (ВОЗ), указанной в разделе Ресурсы ниже.
Информация о текущих клинических исследованиях размещена в Интернете по адресу www.clinicaltrials.gov. Все исследования, финансируемые правительством США, а некоторые исследования, поддерживаемые частной промышленностью, публикуются на этом правительственном веб-сайте.
Для получения информации о клинических испытаниях, проводимых в Клиническом центре NIH в Бетесде, штат Мэриленд, свяжитесь с отделом приема пациентов NIH:
Бесплатный звонок: (800) 411-1222
TTY: (866) 411-1010
Электронная почта: [email protected]
Для получения информации о клинических исследованиях, финансируемых из частных источников, обращайтесь:
www.centerwatch.com
Поддерживающие организации
- Центры по контролю и профилактике заболеваний
- 1600 Clifton Road NE
- Атланта, GA 30333
- Телефон: (404) 639-3534
- Бесплатный звонок: (800) 232-4636
- Электронная почта: [email protected]
- Веб-сайт: http://www.cdc.gov/
- Информационный центр по генетическим и редким заболеваниям (GARD)
- PO Box 8126
- Гейтерсберг, MD 20898-8126
- Телефон: (301) 251-4925
- Бесплатный звонок: (888) 205-2311
- Веб-сайт: http://rarediseases.info.nih.gov/GARD/
- Гранулоцитарный эрлихиоз человека (ГГЭ)
- НИЗ / Национальный институт аллергии и инфекционных заболеваний
- НИАИД Управление по связям с общественностью
- 5601 Fishers Lane, MSC 9806
- Bethesda, MD 20892-9806
- Телефон: (301) 496-5717
- Бесплатный звонок: (866) 284-4107
- Электронная почта: [email protected]
- Веб-сайт: http://www.niaid.nih.gov/
- Всемирная организация здравоохранения (ВОЗ)
- Авеню Аппиа 20
- Женева 27, 1211 Швейцария
- Телефон: 41227912111
- Веб-сайт: http://www.who.int/en/
Рекомендации
УЧЕБНИКИ
Принципы внутренней медицины Харрисона, 13-е изд .: Курт Дж. Иссельбахер, доктор медицинских наук и др., Редакторы; McGraw-Hill, Inc., 1994. P. 756.
Манделл, Дуглас и Беннетт Принципы и практика инфекционных заболеваний, 4-е изд .: Джеральд Л. Манделл, доктор медицины и др., Редакторы; Черчилль Ливингстон Инк., 1995. Стр. 1747-52, 2143.
Инфекционные заболевания: Шервуд Л. Горбач, Джон Г. Бартлетт и Нил Р. Блэклоу, редакторы; WB Saunders Company, 1992. Pp. 1312-14.
ЖУРНАЛЬНЫЕ СТАТЬИ
Эрлихиоз: клещи, собаки и доксициклин. Дж. Л. Гудман; New Eng J Med (15 июля 1999 г .; 341 (3)). Pp. 195-96.
Эрлихия Эвингий, недавно признанный агент эрлихиоза человека. Р.С. Буллер и др .; New Eng J Med (15 июля 1999 г .; 341 (3)). Pp. 148-55.
Эрлихиоз: клещи, собаки и доксициклин (редакция). Дж. Л. Гудман; New Eng J Med (15 июля 1999 г .; 341 (3)).
Человеческий эрлихиоз в США. JH McQuiston et al .; Новые инфекционные заболевания (1999; 5 (5). Центры по контролю заболеваний.
Оленьи клещи (Ixodes Scapularis) и агенты болезни Лайма и гранулоцитарного эрлихиоза человека в парке Нью-Йорка. TJ Daniels et al .;Новые инфекционные заболевания (1997; 3 (3)). Pp. 353-55.
Одновременный гранулоцитарный эрлихиоз человека и боррелиоз Лайма.Р.Б. Надельман и др .; New Eng J Med (3 июля 1997 г .; 337 (1)). Pp. 27-30.
Распространенность риккетсиозного агента гранулоцитарного эрлихиоза человека у клещей с гиперэндемическим очагом болезни Лайма (письмо). И. Шварц и др .; New Engl J Med (3 июля 1997 г .; 337 (1)). Pp. 49-50.
Прямое культивирование возбудителя гранулоцитарного эрлихиоза человека. Дж. Л. Гудман и др .; New Eng J Med (25 января 1996 г .; 334 (4)). Pp.209-15.
Эрлихиоз — в поисках новой инфекции (редакция). W. Schaffner et al .; New Eng J Med (25 января 1996 г .; 334 (4)). Pp. 262-63.
Случай одновременного представления человеческого эрлихиоза и болезни Лайма в Коннектикуте. FM Mazzella et al .; Conn Med (1996; 60). Pp. 515-19.
Клинический спектр раннего боррелиоза Лайма у пациентов с подтвержденной культурой мигрирующей эритемы. Р.Б. Надельман и др .; Am J Med (1996; 100). Pp. 502-08.
Гранулоцитарный эрлихиоз человека: серия случаев из медицинского центра в штате Нью-Йорк. ME Aguero-Rosenfeld et al .; Ann Intern Med (1996; 125). Pp. 904-08.
Появление эрлихиозов как проблем здоровья человека. DH Walker et al .;Новые инфекционные заболевания (январь-март 1996 г .; 2 (1)). Pp. 1-16.
Сероэпидемиология инфекций, вызванных видами пятнистой лихорадки Rickettsiae и Ehrlichia среди военного персонала, обнаруженного в районах Соединенных Штатов, где такие инфекции являются эндемичными. SJ Yevich et al .; J Infect Dis (май 1995 г .; 171 (5)). Pp. 1266-73.
Серологические перекрестные реакции между Ehrlichia Equi, Ehrlichia Phagocytophila и Granulocytic Ehrlichia человека. JS Dumler et al .; J Clin Microbiol (май 1995 г .; 33 (5)). Pp. 1098-103.
Эрлихиоз в пенсионном сообществе, ориентированном на гольф. SM Standaert et al .; New Eng J Med (17 августа 1995 г .; 333 (7)). Pp. 420-25.
Ixodes Dammini как потенциальный вектор гранулоцитарного эрлихиоза человека. П. Панчоли и др .; J Infect Dis (1995; 172). Pp. 1007-12.
Гранулоцитарный эрлихиоз человека на верхнем среднем западе США.Новые виды появляются? JS Bakken et al .; JAMA (20 июля 1994 г .; 272 (3)). Pp.212-18.
Идентификация гранулоцитотропных видов эрлихий как этиологического агента заболеваний человека. С. М. Чен и др .; J Clin Microbiol (март 1994 г .; 32 (3)). Pp. 589-95.
Человеческий эрлихиоз у взрослых после воздействия клеща. Диагностика с использованием полимеразной цепной реакции. Э.Д. Эверетт и др .; Ann Intern Med (1 мая 1994 г .; 120 (9)). Pp. 730-35.
Серологическое подтверждение эрлихиоза человека в Африке. П. Бруки и др .; Eur J Epidemiol (декабрь 1994 г .; 10 (6)). Pp. 695-98.
Случай человеческого эрлихиоза, приобретенного в Мали: клинические и лабораторные данные. IJ Uhaa et al .; Am J Trop Med Hyg (Feb 1992; 46 (2)). Pp.161-64.
In vitro восприимчивость к антибиотикам недавно признанного агента эрлихиоза у людей, Ehrlichia Chaffeensis. П. Бруки и др .; Antimicrob Agents Chemother (Dec 1992; 36 (12)). Pp. 2799-803.
Выявление этиологического агента эрлихиоза человека методом полимеразной цепной реакции. BE Андерсон и др .; J Clin Microbiol (апрель 1992 г .; 30 (4)). Pp. 775-80.
В пробирке восприимчивость Эрлихия Сеннецу к антибиотикам. П. Бруки и др .; Antimicrob Agents Chemother (Aug 1990; 34 (8)). С. 1593-96.
Годы Опубликовано
1996, 1997, 1998, 1999, 2000, 2009
Информация в базе данных редких заболеваний NORD предназначена только для образовательных целей и не предназначена для замены совета врача или другого квалифицированного медицинского работника.
Содержание веб-сайта и баз данных Национальной организации по редким заболеваниям (NORD) защищено авторским правом и не может быть воспроизведено, скопировано, загружено или распространено каким-либо образом для коммерческих или общественных целей без предварительного письменного разрешения и одобрения NORD. , Физические лица могут распечатать одну печатную копию отдельного заболевания для личного использования, при условии, что содержание не изменено и включает авторские права NORD.